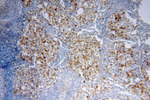
NHE8 Antibody in Immunohistochemistry (Paraffin) (IHC (P))

Search
Proteintech
NHE8 Polyclonal Antibody
{{$productOrderCtrl.translations['antibody.pdp.commerceCard.promotion.promotions']}}
{{$productOrderCtrl.translations['antibody.pdp.commerceCard.promotion.viewpromo']}}
{{$productOrderCtrl.translations['antibody.pdp.commerceCard.promotion.promocode']}}: {{promo.promoCode}} {{promo.promoTitle}} {{promo.promoDescription}}. {{$productOrderCtrl.translations['antibody.pdp.commerceCard.promotion.learnmore']}}
产品信息
18318-1-AP
种属反应
宿主/亚型
分类
类型
抗原
偶联物
形式
浓度
规格
纯化类型
保存液
内含物
保存条件
运输条件
产品详细信息
Immunogen sequence: IRLMDIEDA KAHRRNKKDV NLSKTEKMGN TVESEHLSEL TEEEYEAHYI RRQDLKGFVW LDAKYLNPFF TRRLTQEDLH HGRIQMKTLT NKWYEEVRQG PSGSEDDEQE LL (471-581 aa encoded by BC112213)
靶标信息
Sodium-hydrogen exchangers (NHEs), such as SLC9A8, are integral transmembrane proteins that exchange extracellular Na+ for intracellular H+. NHEs have multiple functions, including intracellular pH homeostasis, cell volume regulation, and electroneutral NaCl absorption in epithelia (Xu et al., 2008).
仅用于科研。不用于诊断过程。未经明确授权不得转售。
篇参考文献 (0)
生物信息学
蛋白别名: DKFZp686C03237; FLJ42500; MGC138418; Na(+)/H(+) exchanger 8; NHE-8; NHE-8 antibody; SLC9A8 antibody; Sodium/hydrogen exchanger 8; solute carrier family 9 (sodium/hydrogen exchanger), member 8; Solute carrier family 9 member 8; solute carrier family 9, subfamily A (NHE8, cation proton antiporter 8), member 8; unnamed protein product
基因别名: 1200006P13Rik; 6430709P13Rik; AI182282; KIAA0939; NHE-8; NHE8; SLC9A8
UniProt ID: (Human) Q9Y2E8, (Rat) Q4L208, (Mouse) Q8R4D1
Entrez Gene ID: (Human) 23315, (Rat) 311651, (Mouse) 77031